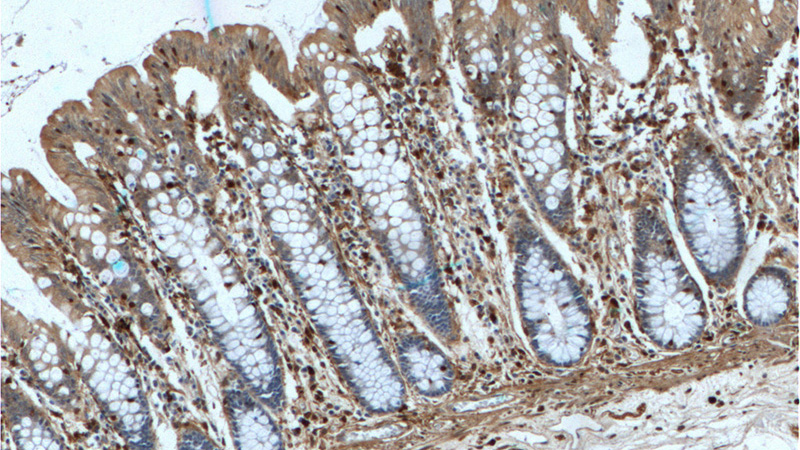
Immunohistochemistry of paraffin-embedded human colon tissue slide using Catalog No:107294(Gelsolin Antibody) at dilution of 1:200 (under 10x lens).
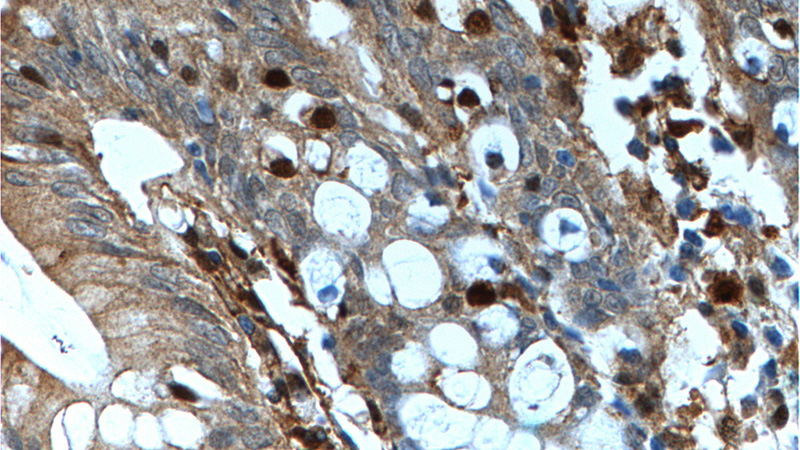
Immunohistochemistry of paraffin-embedded human colon tissue slide using Catalog No:107294(Gelsolin Antibody) at dilution of 1:200 (under 40x lens).

-
Product Name
Gelsolin antibody
- Documents
-
Description
Gelsolin Mouse Monoclonal antibody. Positive IHC detected in human colon tissue, human colon cancer tissue. Positive WB detected in human plasma tissue, A549 cells. Observed molecular weight by Western-blot: 80-83 kDa
-
Tested applications
ELISA, WB, IHC
-
Species reactivity
Human; other species not tested.
-
Alternative names
Actin depolymerizing factor antibody; ADF antibody; AGEL antibody; Brevin antibody; Gelsolin antibody; GSN antibody
- Immunogen
-
Isotype
Mouse IgA
-
Preparation
This antibody was obtained by immunization of Gelsolin recombinant protein (Accession Number: NM_000177). Purification method: Thiophilic affinity chromatograph.
-
Clonality
Monoclonal
-
Formulation
PBS with 0.02% sodium azide and 50% glycerol pH 7.3.
-
Storage instructions
Store at -20℃. DO NOT ALIQUOT
-
Applications
Recommended Dilution:
WB: 1:1000-1:10000
IHC: 1:20-1:200
-
Validations

human plasma tissue were subjected to SDS PAGE followed by western blot with Catalog No:107294(Gelsolin Antibody) at dilution of 1:2000
Immunohistochemistry of paraffin-embedded human colon tissue slide using Catalog No:107294(Gelsolin Antibody) at dilution of 1:200 (under 10x lens).
Immunohistochemistry of paraffin-embedded human colon tissue slide using Catalog No:107294(Gelsolin Antibody) at dilution of 1:200 (under 40x lens).
-
Background
Gelsolin (GSN) is an actin binding protein that regulates actin-severing/depolymerizing in a calcium dependent manner, and acts as a multifunctional regulator for cell metabolism and survival. Gelsolin exists in two isoforms: a cytoplasmic gelsolin (cGSN; 80-90 kDa) and a plasma gelsolin (pGSN; 93 kDa), differing at N terminal residues. Decreased levels of pGSN are strongly associated with human diseases, such as, acute liver injury, major trauma, myocardial infarction, inflammation, lung injury, rheumatoid arthritis, hemodialysis, multiple sclerosis, Alzheimer's disease.
Related Products / Services
Please note: All products are "FOR RESEARCH USE ONLY AND ARE NOT INTENDED FOR DIAGNOSTIC OR THERAPEUTIC USE"
